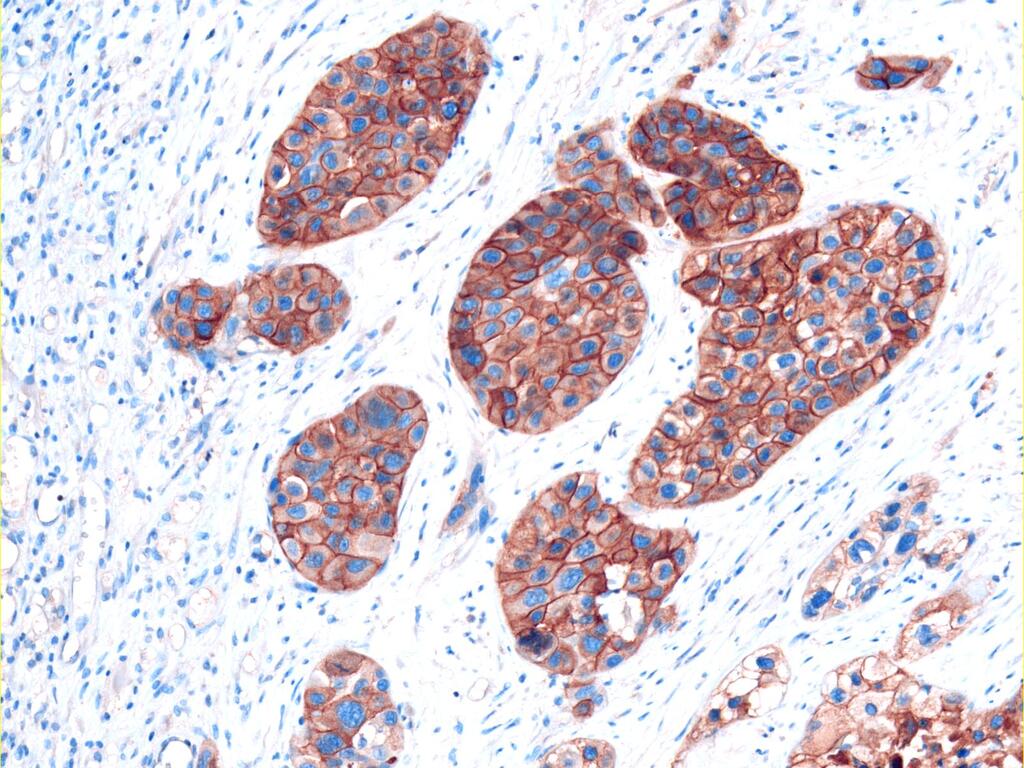

Recombinant monoclonal rabbit antibodies targeting clinically relevant extracellular domains. Validated for IHC on FFPE
tissue and ELISA-based profiling.

Let us stain and analyze your samples.
We offer IHC services using one or more
of our antibodies to reveal spatial patterns
and co-expression in tissue panels.

Need a recombinant antibody against
a novel or unlisted target? We develop
CHO-expressed, IHC-compatible antibodies based on your research needs.
Our recombinant antibodies are designed to target therapy-relevant extracellular domains—the same regions recognized by therapeutic antibodies, ADCs, and CART cells. The highly conformational epitopes bound by these therapeutics are usually lost during formalin fixation and antigen retrieval. In contrast, our antibodies bind linear epitopes within the same domains, enabling reliable detection in FFPE tissue and making them ideal for IHC-based biomarker research.
Each antibody is a recombinant monoclonal rabbit IgG with domain-specific binding validated in IHC on FFPE samples and ELISA-based profiling.

Linear epitopes in the same domains recognized by therapeutic antibodies and CAR-Ts.

Reliable IHC performance using standard fixation and antigen retrieval protocols.

Monoclonal rabbit IgGs produced
recombinantly for lotto-lot consistency

Binds Domain III of HER3, the extracellular region targeted by therapeutic antibodies like Patritumab Deruxtecan and Lumretuzumab.

Binds Domain III of HER3, the extracellular region targeted by therapeutic antibodies like Patritumab Deruxtecan and Lumretuzumab.

Binds Domain III of HER3, the extracellular region targeted by therapeutic antibodies like Patritumab Deruxtecan and Lumretuzumab.
See how our domain-specific antibodies enable multiplexed IHC to visualize the co-expression and spatial heterogeneity of drug targets within the same tumor sample.
Using our IHC-validated antibodies in multiplex panels, researchers can investigate multiple therapy-relevant targets within the same FFPE section while preserving spatial context. This allows for detailed visualization of co-expression patterns, mutual exclusivity, and the distribution of drug targets across distinct tumor cell subpopulations, providing insights that are not accessible through bulk or single-marker analyses.
We offer high-throughput staining, imaging, and reporting using our domain specific antibodies—ideal for biomarker profiling across tumor panels.
We offer scalable IHC and multiplex staining services using one or more of our antibodies. This service is ideal for projects that require analysis across large sample sets, such as biomarker profiling across different tumor entities or validation of domain-specific expression patterns.
We provide staining, imaging, and result reporting on customer-supplied or commercially sourced FFPE tissue sections.
Starting at only 19 € per tumor sample*
*with a minimum order of 100 samples and depending on tumor entity
We create CHO-expressed, domain-specific recombinant antibodies tailored to your research needs. All antibodies are monoclonal and validated for IHC on FFPE tissue.
If your project focuses on a target not included in our main catalog, we offer
antibody development services tailored to your research needs. All services are based on our proprietary core platform of domain-specific, CHO-expressed, monoclonal antibodies validated for use in FFPE IHC.

Newsletter
Subscribe to our newsletter for exclusive updates on new domain-specific antibodies, validation data, and application insights. Be the first to learn about product launches, service offers, and the latest findings in translational and therapeutic research—delivered straight to your inbox.